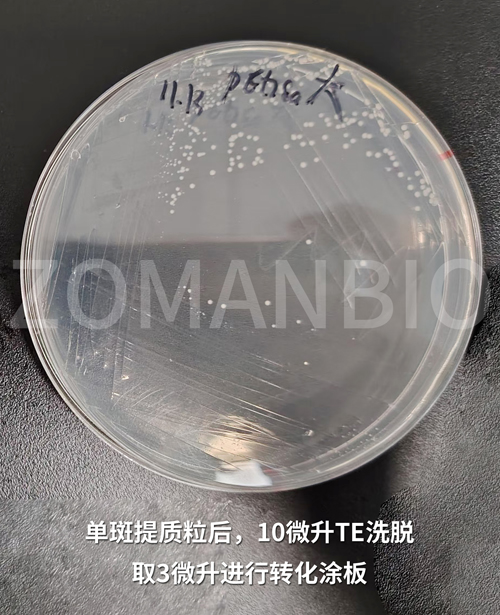

儲存條件:
本試劑盒在室溫(15-25℃)干燥條件下,可保存1年;更長時間的保存可置于2-8℃。若溶液產(chǎn)生沉淀,應(yīng)在使用前置于37℃下溶解沉淀。單獨(dú)包裝的RNase A 在-20℃可穩(wěn)定保存1年以上。加入RNase A后的溶液M1應(yīng)置于2-8℃保存,可穩(wěn)定保存半年以上。
產(chǎn)品簡介:
本試劑盒采用堿裂解法裂解細(xì)菌,再通過離心吸附柱在高鹽狀態(tài)下特異性地結(jié)合溶液中的DNA。離心吸附柱中采用的硅基質(zhì)材料為本公司特有新型材料,高效、專一吸附微量DNA。本說明書操作步驟適用于從0.1ml過夜培養(yǎng)的大腸桿菌LB (Luria-Bertani) 培養(yǎng)液中或者是單菌落中,快速提取多至500ng純凈的高拷貝質(zhì)粒DNA。
使用本試劑盒提取的質(zhì)粒DNA可適用于各種常規(guī)操作,包括PCR、轉(zhuǎn)化等。
質(zhì)粒轉(zhuǎn)化效果圖: